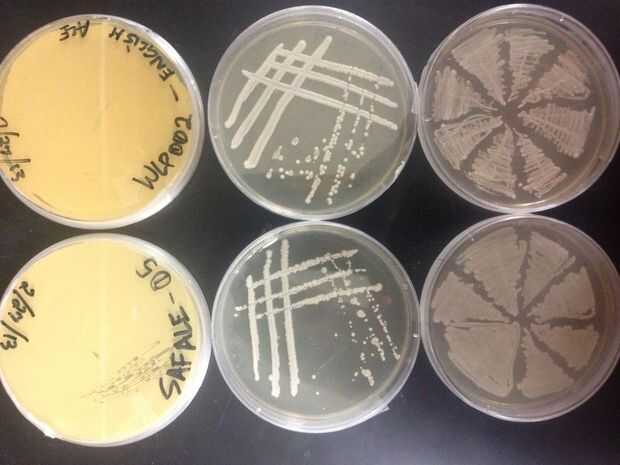

Paso 7: Use la lámpara de alcohol para la llama esterilizar instrumentos y proporcionar un área de trabajo limpia
![]()
![]()
La lámpara de alcohol crea una corriente ascendente y proporciona el aire limpio de contaminantes en el aire inmediatamente en las cercanías de la llama, que puede utilizar para trabajar con medios de cultivo estéril en cajas Petri para inicio experimentos microbiológicos. En mi siguiente Instructable le mostrará cómo hacer placas estériles con medio de cultivo sólido (nutriente de levadura, extracto de Malta, agar-agar) para la cultura pura de levadura en casa.